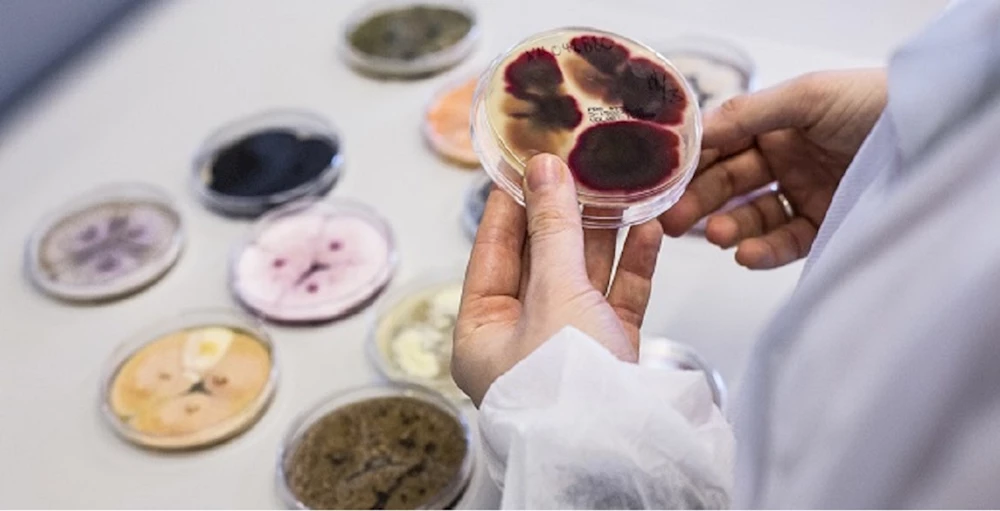

15750,07%-2,31
43,96% 0,03
51,10% -0,61
7260,62% -3,65
11848,56% -2,98
Sanayi Devrimi ile birlikte hayatımıza giren ve günümüzde iklim krizi olarak adlandırılan ve çağımızın en büyük sorunu küresel ısınmanın en büyük sebebi karbon ve sera gazı emisyonlarındaki artış. Yaklaşık 300 yıl önce başlayan ve etkilerine bugün daha fazla odaklandığımız Sanayi Devrimi ile birlikte başlayan doğal kaynakların hızla bozulması ve tüketilmesi bugün en üst seviyelerde. Öyle ki bugün geçmişe göre 1.5 dünya hızında tüketiyoruz.
Doğal kaynakların hoyrat kullanımı ve tüketimi sonucu kirlenen hava, su ve toprak kaynakları, iklim değişiklikleri, temiz gıdaya ulaşım, eşit şartlarda yaşam gibi olgular günümüzde sürdürülebilirlik kavramını çokça duymamıza ve bu anlamda önlemler almak için farkındalık artırıp hayata geçirmemize sebep oldu.
Doğal dengenin yeniden inşası için çalışıyoruz
Bozulan dengenin yeniden onarılması için bireysel alınan önlemlerin yanında endüstrilerin de ekonomik kalkınma ile birlikte çevre ve temiz ve sağlıklı gıda için çalışmalarını hayata geçirmesi gerekiyor. Doğadan aldığımızı yeniden yerine koymak adına önemli adımlar atan şirketlerden bir tanesi olan Novozymes, sürdürülebilirliğe odaklanarak dünyanın acil ihtiyaçlarına doğa ve bilim kaynaklı çözümler sunuyor.
Novozymes A/S'nin iştiraki olarak 25 yıldır Türkiye’de faaliyet gösteren şirket, yerel sanayiye ve ekonomiye katkıda bulunmak ve müşterilerine özel çözümlerle hizmet vermek için yeteneklerini geliştirerek hizmet ağını ve sunduğu çözüm kapasitesini artırmaya devam ediyor.
Geçtiğimiz günlerde Türkiye’deki faaliyetlerinin 25. yılını kutladıkları etkinlikle konuşan Novozymes Türkiye Ülke Müdürü ve Orta Doğu Tüketici Biyolojik Çözümleri Direktörü Pınar Tunçkol, Novozymes’ın sunduğu bilime dayalı biyoçözümler sayesinde ev temizlik ürünleri, insan sağlığı, deri ve tekstil ürünleri, biyoenerji, su ve su atıkları, gıda ve tarım gibi 40 endüstriden kaynaklanan karbon emisyonlarının azaltılmasını destekleyip, üretimin daha verimli olmasını sağladıklarını ve gıda israfını engelleyen çözümleri ile dünyanın sınırlı kaynaklarını daha etkin kullanılmasına olanak sağladıklarını ifade etti.
Gıda israfı karbon ayak izini artırıyor
Pınar Tunçkol, konuşmasına şöyle devam etti: “Tüm dünyada gıda israfı ve kaybının yıllık karbon ayak izinin 3,3 milyar ton olduğu düşünülüyor ve gıda atıklarının yüzde 61’i mutfaklarımızdan çıkıyor. Örneğin; insanların yüzde 20’den fazlası ekmek kuruduğunda, son kullanma tarihi gelmese dahi çöpe attıklarını ifade ediyor. İstanbul’da bulunan Teknoloji ve İnovasyon Merkezi de dahil olmak üzere Novozymes’in ürettiği ve ekmeğin daha uzun süre taze kalmasını sağlayan enzimler sayesinde, yaklaşık 30 yılda tahminen 80 milyar somun ekmeğin çöpe atılması önlendi ve 45 milyon ton karbondioksit salınımı engellenmiş oldu. Novozymes, farklı sektörlerde ürettiği enzimler ile sağladığı üretkenlik, verimlilik ve kaynakların doğru kullanımı sayesinde üretimden, tüketimden veya israftan kaynaklanan milyonlarca ton karbondioksit salınımını engelliyor.”
Tunçkol son olarak şunları söyledi: “Türkiye’deyiz çünkü, ülkemizin gücüne inanıyor ve buradaki üreticilerimizin yerelden globale üretimlerini destekleyerek onların ihtiyaçlarına özel çözümler sunabilmek istiyoruz. Biz, inovasyonlarımızı, içerisinde bulunduğumuz coğrafyayı anlayarak ve ona özel çözümler üreterek yaratıyoruz. Doğanın gücünü ve potansiyelini kullanarak dünyanın ve ülkemizin geleceğini şekillendirmek üzere çalışıyoruz. Çalışma felsefemizin ve çözümlerinizin ardında yatan bilim sayesinde endüstrilere ve tüketicilere yarınımızı yeniden düşünme çağrısında bulunuyoruz. Ortak geleceğimiz için ilerici adımlar atabilmek adına onları çözümlerimiz ile destekliyoruz ve cesaretlendiriyoruz.”
